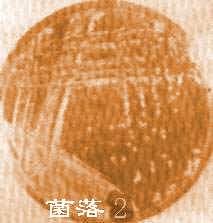
細菌門

概述
細菌和藍藻都是原核生物,分布很廣,水、空氣、土壤和許多動植物的體內也都有細菌。它們是單細胞植物,沒有具膜的核,一般無色素。
細菌的營養方式多數為異養,有的是從活的動植物體內吸收有機物,稱寄生細菌。寄生細菌能致人畜的疾病和植物病害。如水稻白葉枯病、棉花角斑病、花生青枯病以及蔬菜軟腐病。
有的是從動植物遺體或其它有機物取得有機物,稱腐生細菌。腐生細菌常使食物腐爛,地球上的碳、氮循環,綠色植物生活的原料,必須經過腐生細菌的腐爛方可吸收。
有的細菌,如根瘤菌能攝取大氣中的氮,製成有機氮,供綠色植物生長,稱為共生。
放線菌為細菌中的一類,細胞桿狀,不遊動,在某種生活情形下成分枝絲狀體。有些屬能產生抗菌素,常見的有鏈黴素、四環素、土黴素等。
命名方法
 顯微鏡下的細菌
顯微鏡下的細菌通常,細菌門命名方法有三種:
1.新種的命名 在學名之後加注n.sp.(novospecies)。屬名後加上sp.或spp.。科名字尾為-aceae,目為-ales,綱為-tes,門為-phyta。
2.變種的命名 在學名之後加上變種名稱,在變種之前加注var.(variety),若為新變種,注以n.var.。
3.習慣通用的俗名如typhoidbacillus傷寒桿菌。
發現
17世紀後葉,荷蘭人列文·虎克自製了世界上第一台顯微鏡,並用它觀察到了細胞和細菌的存在,他是世界上第一個看到細菌的人。
形態特徵
細菌門的形態通常可分為三種基本類型:球菌:細胞球形,直徑0.5~2微米;桿菌:細胞呈桿棒狀,
 細菌門的繁殖
細菌門的繁殖在螺鏇菌中,一次彎曲成弧形的稱弧菌(Vibrio),多次彎曲呈螺鏇形的稱螺菌(Spirillum)。多種桿菌、螺菌和弧菌生有鞭毛,鞭毛是外原生質突出的長絲,其長度往往超過菌體長度的數倍或數十倍,在電子顯微鏡下,或經過特殊處理後才能看到。
細胞的構造和一般植物細胞類似,有細胞壁、細胞膜、細胞質、核質和內含物。有的細菌還有莢膜(capsule)、芽孢和鞭毛。
細菌細胞壁的化學成分為粘質複合物,細胞內充滿了細胞質,細胞質的外圍是細胞膜,緊靠細胞壁。細胞幼小時,細胞質密而均勻,無內含物,容易著色。細胞成熟後,細胞質分布不均勻並含有肝糖、澱粉、脂肪、異染顆粒等物質。
細菌門菌類沒有真正的細胞核,核質分散於細胞質中,稱為原核(prokaryo),核質內有脫氧核糖核酸。
多數細菌在一定條件下,細胞壁的周圍包被著1層粘性的薄膜,稱為莢膜,它是1層透明的膠狀物質,由多糖類物質組成,有保護細胞的作用。
某些種細菌生長到某個階段,失去水分濃縮,形成1個圓形或橢圓形的內生孢子,稱為芽孢。芽孢的壁很厚,滲透性很弱,含水少,能抵抗不良的環境,可生存十幾年,遇到適宜的環境,再發生新的菌體,1個芽孢只產生1個菌體。
繁殖方式
細菌門菌類主要進行無性生殖,除少數種類外,分裂繁殖是細菌的唯一繁殖方法。在適宜的環境下進行
 革蘭氏陽性細菌
革蘭氏陽性細菌細菌門的裂殖速度極快,在最適的條件下,20—30分鐘就能分裂1次,並可繼續分裂若干次。如果1晝夜不停地繼續分裂,所產生的後代要用天文數字來計算,但實際上不可能有如此驚人的高速度,因為分裂時需要充分的營養和一定的溫度,當繼續分裂時,常因養料供給不足,或溫度的變化以及其他種種原因而停止分裂或死亡。
營養方式
細菌門的營養方式多數為異養,有的是從活的動植物體內吸收有機物,稱寄生細菌。寄生細菌能致人畜的疾病和植物病害。如水稻白葉枯病、棉花角斑病、花生青枯病以及蔬菜軟腐病。
有的是從動植物遺體或其它有機物取得有機物,稱腐生細菌。腐生細菌常使食物腐爛,地球上的碳、氮循環,綠色植物生活的原料,必須經過腐生細菌的腐爛方可吸收。
有的細菌,如根瘤菌能攝取大氣中的氮,製成有機氮,供綠色植物生長,稱為共生。
分類方法
(一)生理學與生物化學分類法
細菌門菌類的形態,染色以及細菌的特殊結構是最早和最基本的分類依據;而細菌的生理生化特徵一
 細菌
細菌以生理生化學作細菌分類的廣泛採用方法有兩種,即傳統分類法和數值分類法。
1.傳統分類法:傳統分類的原則是將生物的基本性質分為主要的和次要的(主次原則),然後將主次順序一級一級地往下分,直至最小區分。按細胞形態、革蘭染色性、鞭毛及代謝特點作為較高一級分類依據。科、屬、種水平的分類主要依靠生化特性和抗原結構。
2.數值分類法:數值分類法集數字、電子、信息及自動化分析技術於一體,將細菌的一些基本性質視為同等重要(等重要原則),採用標準化、成品化和配套生化反應試劑條,檢測細菌的數十個生理生化特性。每個細菌都能產生一套陰陽性結果,然後轉換成數字,通過電子計算機進行複雜計算,比較每一株與其他類同株,測定其相似度。根據相似度,區分細菌的種群,並確定各種細菌的親緣關係。
(二)遺傳學分類法
遺傳學分類是以細菌的核酸、蛋白質等在組成的同源程度分類。該分類法具有下述的優點:①對細菌的“種”有一個較為一致的概念;②使分類不會出現經常性或根本性的變化;③可制定可靠的細菌鑑定方案;④有利於了解細菌的進化和原始親緣關係。目前較為穩定的套用遺傳學的細菌分類方法有下列幾種:
1.DNAG+Cmol%測定。
2.核酸同源值測定。
3.核糖體RNA鹼基序列測定。
下屬分類
細菌門按其外形主要有三類,球菌、桿菌、螺形菌。
 細菌種類
細菌種類一、球菌(Coccus)
呈圓球形或近似圓球形,有的呈矛頭狀或腎狀。單個球菌的直徑約在0.8~1.2um左右。由於繁殖時細菌細胞分裂方向和分裂後細菌粘連程度及排列方式不同可分為:
(一)雙球菌(Diplococcus):在一個平面上分裂成雙排列,如肺炎雙球菌、腦膜炎雙球菌。
(二)鏈球菌(Streptococcus):在一個平面上分裂,成鏈狀排列,如溶血性鏈球菌。
(三)四聯球菌(Micrococcustetragenus):在兩個相互垂直的平面上分裂,以四個球菌排呈方形,如四聯加夫基菌。
(四)八迭球菌(Sarcina):在三個互相垂直的平面上分裂,八個菌體重疊呈立方體狀,如藤黃八疊球菌。
(五)葡萄球菌(Staphylococcus):在幾個不規則的平面上分裂,則菌體多堆積在一起,而呈葡萄狀排列,如金黃色葡萄球菌。
二、桿菌(Bacillus)
各種桿菌的大小、長短、彎度、粗細差異較大。大多數桿菌中等大小長2~5um,寬0.3~1um。大的桿菌如炭疽桿菌(3~5um×1.0~1.3um),小的如野兔熱桿菌(0.3~0.7um×0.2um)。菌體的形態多數呈直桿狀,也有的菌體微彎。菌體兩端多呈鈍圓形,少數兩端平齊(如炭疽桿菌),也有兩端尖細(如梭桿菌)或
 有莢膜的細菌結構
有莢膜的細菌結構三、螺形菌(Spirillarbacterium)
菌體彎曲,可分為:
(一)弧菌(Vibrio):菌體只有一個彎曲,呈弧狀或逗點狀。如霍亂弧菌。
(二)螺菌(Spirillum):菌體有數個彎曲。如鼠咬熱螺菌。
細菌門菌類形態可受各種理化因素的影響,一般說來,在生長條件適宜時培養8~18小時的細菌形態較為細菌形態較為典型;幼齡細菌形體較長;細菌衰老時或在陳舊培養物中,或環境中有不適合於細菌生長的物質(如藥物、抗生素、抗體、過高的鹽分等)時,細菌常常出現不規則的形態,表現為多形性(Pleomorphism),或呈梨形、氣球狀、絲狀等,稱為衰退型(Involutionform),不易識別。觀察細菌形態和大小特徵時,應注意來自機體或環境中各種因素所導致的細菌形態變化。
分布
細菌門菌類的種類約有2000種。分布很廣,水、空氣、壤和許多動植物體內外都有細菌的分布。
代表菌
放線菌
 放線菌
放線菌放線菌屬於單細胞。在顯微鏡下,放線菌呈分枝絲狀,我們把這些細絲一樣的結構叫做菌絲,菌絲直徑與細菌相似,小於1微米。根據菌絲形態和功能的不同,放線菌菌絲可分為基內菌絲、氣生菌絲和孢子絲三種。鏈黴菌屬是放線菌中種類最多、分布最廣、形態特徵最典型的類群。
基內菌絲匍匐生長於營養基質表面或伸向基質內部,它們象植物的根一樣,具有吸收水分和養分的功能。
氣生菌絲是基內菌絲長出培養基外並伸向空間的菌絲。在顯微鏡下觀察時,一般氣生菌絲顏色較深,比基內菌絲粗;而基內菌絲色淺、發亮。有些放線菌氣生菌絲髮達,有些則稀疏,還有的種類無氣生菌絲。
孢子絲是當氣生菌絲髮育到一定程度,其上分化出的可形成孢子的菌絲。放線菌孢子絲的形態多樣,有直形、波曲、鉤狀、螺鏇狀、一級輪生和二級輪生等多種,是放線菌定種的重要標誌之一。孢子表面的紋飾因種而異,在電子顯微鏡下清晰可見,有的光滑,有的褶皺狀、疣
 固氮菌
固氮菌固氮菌
在與植物共生的情況下才能固氮或才能有效地固氮,固氮產物氨可直接為共生體提供氮源。共生固氮效率比自生固氮體系高數十倍。主要有根瘤菌屬(Rhizobium)的細菌與豆科植物共生形成的根瘤共生體,弗氏菌屬(Frankia)與非豆科植物共生形成的根瘤共生體;某些藍細菌與植物共生形成的共生體,如念珠藻或魚腥藻與裸子植物蘇鐵共生形成蘇鐵共生體,紅萍與魚腥藻形成的紅萍共生體等。在實驗條件下培養自生固氮菌,培養基中只需加入碳源(如蔗糖、葡萄糖)和少量無機鹽,不需加入氮源,固氮菌可直接利用空氣中的氮(N2)作為氮素營養;如培養根瘤菌,則需加入氮素營養,因為根瘤菌等共生固氮菌,只有與相應的植物共生時,才能利用分子態氮(N2)進行固氮作用。
用途
在自然界的物質循環中,細菌門起著重要的作用。地球上動植物的屍體和排泄物,必須經過腐生
細菌菌落
細菌菌落細菌門在工業、醫藥衛生等方面的套用也很廣。工業上可利用細菌生產多種工業產品,如枯草桿菌生產蛋白酶和澱粉酶,可用於皮革脫毛、絲綢脫膠和棉布脫漿等;乳酸桿菌、醋酸桿菌可分別產生乳酸、醋酸等化工原料;谷氨酸短桿菌生產谷氨酸(谷氨酸鈉即味素)和肌苷酸,用於食品及醫藥。醫藥衛生方面,利用細菌生產預防和治療疾病的疫苗、抗病血清、代血漿以及各種抗生素,例如常見的鏈黴素、四環素、土黴素、氯黴素等,都是從放線菌的代謝物中提取出來的抗生素藥物。
細菌門的有害方面也不容忽視。寄生細菌能引起人、畜、禽及植物發生病害,甚至造成死亡,如痢疾、霍亂、白喉、破傷風等病菌;水稻葉枯病、棉花角斑病、蔬菜軟腐病等病原菌。腐生細菌常致使肉類等食品腐爛,工業生產中常因污染了雜菌而使發酵停止等等。

